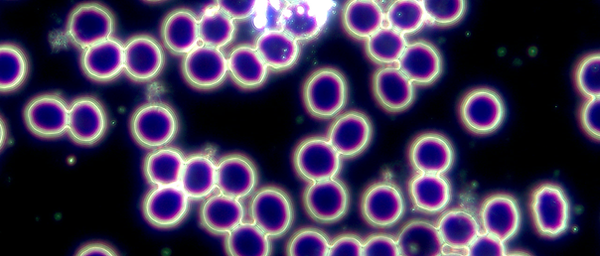

top of page


Über mich
Naturheilkunde
Lengyel Edit természetgyógyász
Több évtizedes egészségügyi és természetgyógyászati tapasztalattal segitem pácienseimet a testi-lelki egyensúly visszaállitásában és megőrzésében.Végzettségeim között szerepel a természetgyógyászat, gyógyszertári asszisztensi,vegyésztechnikusi képesités,valamint a tisztiorvosi háttérismeretek, amelyeket részben külföldön szereztem meg és amelyek stabil szakmai alapot biztositanak a munkámhoz
A manuális terápiákban , valamint az ayurvedikus szemléletű gyógyászat módszereiben egyaránt jártas vagyok .
Holisztikus megközelitéssel dolgozom,amely az ember egészét :testet-lelket-szellemet és az életmódot is figyelembe veszi
Célom hogy személyre szabott megoldásokkal ,individuálisan ,esetenként quantum fizikai eljárásokkal,támogassam a természetes öngyógyitó folymatokat , legyen szó megelőzésről ,rehabiltációról vagy egyszerűen az életminőség javitásról
Munkám alapelve :hogy a stabil alap teremti meg a stabil felépitményt
Ez az emberei szervezetre is igaz:egészségünk valódi pillérjei a sejtjeink,ezért a terápiás szemléletem központjában a sejtszintű támogatás áll, amely a szervezet öngyógyitó folyamatait erősiti, és az oki kezelést teszi lehetővé, a tüneti kezelés helyett
Pácienseim kezelése során olyan módszereket alkalmazok amelyek a legkorszerűbb ,az utóbbi 30 év kutatási eredményein alalpuló alternativ gyógyitás megközelitéseire támaszkodnak.Hiszem hogy csakis igy jöhet létre tartós és mélyreható javulás
Amikor a test alapjai-a sejtek-stabilak ,az energiaszint és az életminőség természetes módon egészséges és elérhetjük az ELÉGEDETTSÉGET ami egyben boldogságot is jelent!
Több mint 30 éve foglalkozok az egészséghez vezető út megmutatásával
Pályámat Magyarországon kezdtem,majd külföldi tartózkodásom alatt -18 éven keresztül-szélesitettem a szakmai tapasztalataimat, és tudásomat.Hiszek abban hogy a modern tudás és az ősi gyógyitó hagyományok összehangolása mindenki számára megmutatja az individuális utat a tartós egészséghez és harmóniához
Rendelésemen biztonságos , empatikus légkörben várom mindazokat ,akik természetes módszerekkel szeretnék támogatni egészségüket és vitalitásukat


*Állapot felmérés
Az állapotfelmérés praxisomban komplex,több szinten zajló vizsgálati rendszerre épül
A szervezet aktuális müködéséről és ezek információjának "olavsására"különböző módszerek állnak rendelkezésemre ,hogy átfogó képet kapjunk a testi egyensúly állapotáról
Az alkalmazott felmérési eszközök között szerepel:
*sötétlátóteres mikroszkópos vizsgálat
*vérvizsgálatok elemzése a labor paraméterek alapján
*arteriográfos érfal-analizis:az erek állapot -felmérésére
*Sötétlátóteres mikroszkópos vér analizis
Látványos betekintés saját szervezeted működésébe:egy csepp friss vér vizsgálata során -élőben-kivetitve figyelhető meg a vörös és fehér vérsejtek mozgása ,dinamikája,a sejtközötti állományban a lerakódások, paraziták,stb..
A vizsgálat segit jobban megérteni -szemléletesen-a test aktuális állapotát, igy támogatja a tudatosabb életmód kialakitását.Ezzel a módszerrel nem csak a betegségek kialakulásának okaira lehet következtetni, hanem azok megelőzésében is nagy szerepe van
A laboratóriumi vizsgálatokkal összevetve segit az okot megtalálni
*HRV-szivritmus variációs készségének a vizsgálata:
Ez a vizsgálat a szervezet individuális "válaszát"mutatja ki a külvilági ingerekre és ezek hatásait ,változásait a szervekre-szivre ,az idegrenszerre és a Chire vonatkoztatva,valamint a biológia korunkat is kimutatja:
*az autonóm, a szimpatikus és a paraszimpatikus idegrendszer aktivitásának feltérképezése, az egyensúly-felmérése
*energetikai állapotfelmérés,beleértve a csakrák ,a meridiánok és az aura vizsgálatát fényképpekkel is igazolva
A cél minden esteben az,hogy a fizikai,élettani és energetikai müködéseket, a szervezet válaszait a külvilág ingereire felmérjük és ennek alapján az egyénre szabott képet kapjunk a valódi fizikális-szellemi-lelki és energetikai aktuális állapotról
Az igy nyert , igen átfogó információk alapot biztositanak a terápiás javaslatok és kezelési irányok meghatározásához
*Anyagcsere felmérés individuális étrend készitéssel
az egészséges fogyás és anyagcsere folymatok aktiválására és ezekből adódó betegségek megelőzésére
Ennek az alapja egy 50 paraméterből álló laborvizsgálat
A vizsgálat célja hogy feltérképezze a szervezet egyéni működédét, és pontos képet adjon arról,hogy mely tápanyagok és élelmiszerek hasznosulnak a leghatékonyabban
Az eredmények alapján személyre szabott ajánlás készül, amely az egyéni biokémiai adottságokhoz igazodik.Ez segit abban ,hogy a bevitt táplálék elsősorban energia termelésre forditódjon ne felesleges raktározásra,ezáltal támogatva az optimális anyagcserét ,a testsúly-egyensúlyt és a vitalitást
*Mitokondriális sejtszintű energiaelőállitási zavarok felmérése és ezek megszüntetésére a tanácsadás:
A sötérlátóteres mikroszkópos vizsgálat a laborerdményekkel,HRV-analizissel és az artériák érfalának mérésével kiegészitve komlex képet ad a szervezet aktuális állapotáról.Az összefüggések feltárása lehetőséget nyújt a sejtszintü-mitokondriális folyamatok megértésére és a célzott ,támogató terápiás irányok meghatározására, a szervezet egyensúlyának és harmónikus müködésének támogatásáért
*Intervallumos hypoxi-hyperoxi terápia:
Ez a kezelés (IHHT)során a páciens váltakozva alacsony és magas oxigéntartalmú levegőt lélegez be maszkon keresztül
Ez a kontrollált oxigénváltozás alkalamazkodási folyamatokat indit el a sejtekben,aktiválja a "Hypoxia inducible faktortt(HIF-1)"rendszert ,javitja a mitokondriumok müködését és a sejtek energia-termelését:ATP
Célja a sejtszintü regeneráció,az anyagcsere és az immunrendszer aktiválása a szervezet terhelhetőségének támogatása,anti aging

bottom of page
